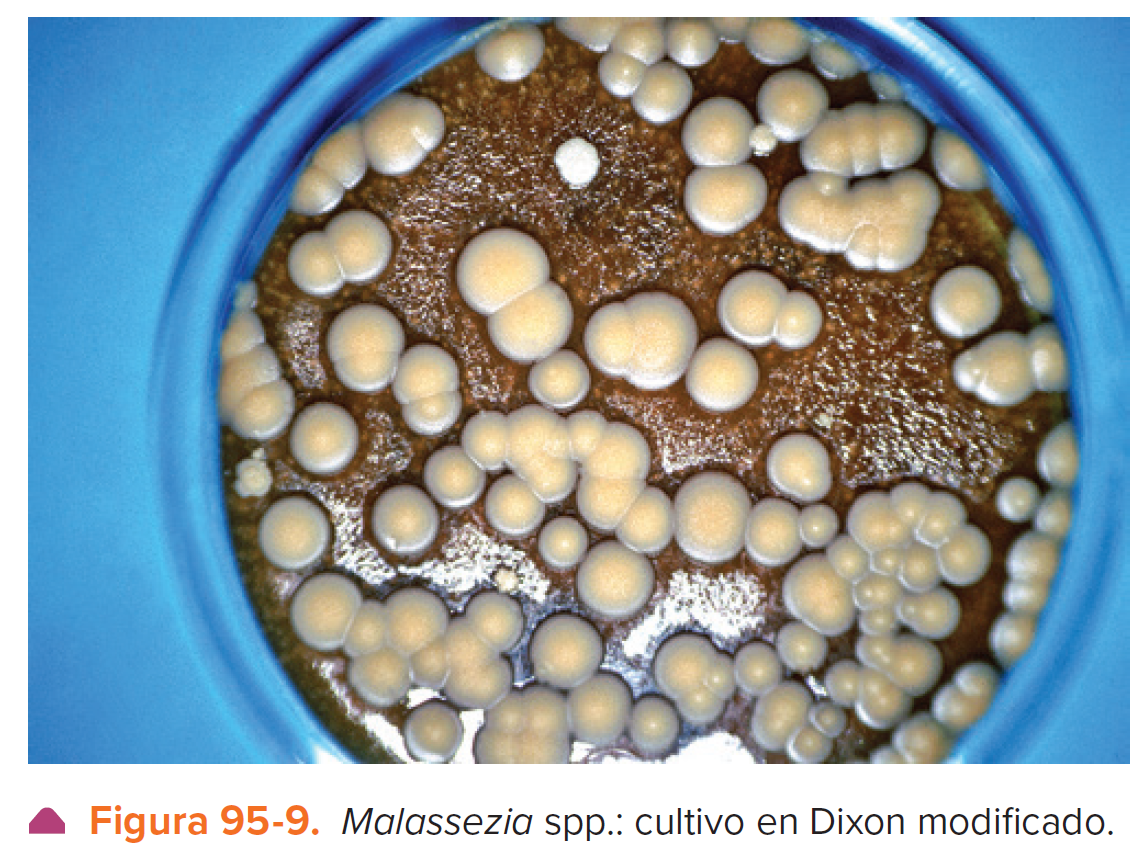

¿CON QUÉ OTROS NOMBRES SE LE CONOCE A LA PITIRIASIS VERSICOLOR?
TIÑA VERSICOLOR.
MAL DE AMORES.
TIÑA FLAVA.
¿LUZ NEGRA POLARIZADA QUE SE UTILIZA PARA DIAGNOSTICAR PADECIMIENTOS MICOTICOS?
LUZ DE WOOD.
¿DEFINICIÓN DE PITIRIASIS VERSICOLOR?
MICOSIS SUPERFICIAL PRODUCIDA POR EL COMPLEJO LIPOFÍLICO MALASSEZIA SPP.; SE CARACTERIZA POR MANCHAS HIPOCRÓMICAS O HIPERCRÓMICAS, CUBIERTAS DE DESCAMACIÓN FINA, QUE PREDOMINAN EN TRONCO, CUELLO Y PARTE SUPERIOR DE LOS BRAZOS; PRESENTA RESPUESTA ADECUADA AL TRATAMIENTO, PERO LAS RECIDIVAS SON FRECUENTES.
¿EPIDEMIOLOGÍA DE LA PITIRIASIS VERSICOLOR?
MICOSIS COSMOPOLITA, ENDÉMICA EN ZONAS TROPICALES.
LA PREVALENCIA VARÍA DE 0.8 A 30 O 50%, PRINCIPALMENTE EN SAMOA, FIJI, CENTROAMÉRICA, SUDAMÉRICA, ALGUNAS REGIONES DE ÁFRICA, CUBA, LAS ANTILLAS Y EL MEDITERRÁNEO.
EN LAS COSTAS DE MÉXICO OCUPA EL PRIMER LUGAR EN LA CONSULTA DERMATOLÓGICA.
PUEDE APARECER A CUALQUIER EDAD, Y AFECTA A AMBOS SEXOS; PREDOMINA EN VARONES, CON UNA PROPORCIÓN DE 2:1; ES MÁS FRECUENTE ENTRE LOS 20 Y 45 AÑOS DE EDAD; SE HA OBSERVADO EN LACTANTES, PERO EN GENERAL ES RARA DURANTE LA NIÑEZ.
HAY ANTECEDENTES FAMILIARES EN 19% DE LOS AFECTADOS.
¿ETIOPATOGENIA DE PITIRIASIS VERSICOLOR?
MALASSEZIA SPP. (PITYROSPORUM OVALE, P. ORBICULARE) ES UN HONGO LEVADURIFORME Y LIPOFÍLICO QUE FORMA PARTE DE LA FLORA NORMAL CUTÁNEA.
ANTES SE CREÍA QUE MALASSEZIA Y PITYROSPORUM REPRESENTABAN LAS FASES MICELIAL Y LEVADURIFORME, PERO HOY DÍA AMBOS SE INCLUYEN EN EL GÉNERO MALASSEZIA. SIN EMBARGO, LA MICROBIOTA DE ESTE HONGO ES MUY COMPLEJA E INCOMPRENSIBLE EN LA PIEL HUMANA, Y ES MUY PROBABLE QUE EXISTA UNA RELACIÓN ENTRE LA EXPRESIÓN DE GENES DEL HOSPEDERO Y EL DESARROLLO DE LA ENFERMEDAD.
LOS ESTUDIOS MOLECULARES HAN MOSTRADO DIFERENTES SUBTIPOS DE LAS ESPECIES Y DIVERSIDAD INTRAESPECÍFICA. YA SE HAN DESCRITO EL GENOMA COMPLETO DE M. GLOBOSA Y M. SYMNPODIALIS, Y PARCIALMENTE DE M. RESTRICTA.
LA PITIRIASIS VERSICOLOR ES FAVORECIDA POR EL CALOR, LA HUMEDAD, LA SUDORACIÓN, PRODUCCIÓN DE SEBO, USO DE ROPA OCLUSIVA DE MATERIAL SINTÉTICO, Y APLICACIÓN DE GRASAS Y GLUCOCORTICOIDES TÓPICOS O SISTÉMICOS, SÍNDROME DE CUSHING, INMUNOSUPRESIÓN, DEFECTO DE LA PRODUCCIÓN DE LINFOCINAS O DIABETES. MALASSEZIA SPP.
ES CAPAZ DE INDUCIR UNA RESPUESTA INFLAMATORIA CON INFILTRADO LEVE CONSTITUIDO POR LINFOCITOS CD4+.
EN LOS PACIENTES CON PITIRIASIS VERSICOLOR SE HAN ENCONTRADO ALTERACIONES EN LA RESPUESTA HUMORAL, CON AUMENTO EN LA PRODUCCIÓN DE IgG, ASÍ COMO UN DEFECTO DE LA PRODUCCIÓN DE LINFOCINAS, CON DESAPARICIÓN DE CÉLULAS T REACTIVAS EN SANGRE PERIFÉRICA Y DISMINUCIÓN DE LA PRODUCCIÓN DE INTERLEUCINA (IL)-2 E INTERFERÓN (IFN) - ALFA.
SE HA IDENTIFICADO UN RECEPTOR EN MACRÓFAGOS CONOCIDO COMO “MINCLE” QUE RECONOCE LA MANOSA EN LAS PAREDES CELULARES DE MALASSEZIA E INTERACTÚA CON LA MISMA, LO QUE DESENCADENA SU ACTIVACIÓN Y CONSIGUIENTE PRODUCCIÓN DE CITOCINAS Y QUIMIOCINAS.
PARECE QUE LA DESCAMACIÓN DEPENDE DEL EFECTO QUERATOLÍTICO DEL HONGO, O DE LA TRANSFORMACIÓN DE TRIGLICÉRIDOS EN ÁCIDOS GRASOS IRRITANTES; LOS CAMBIOS DE LA COLORACIÓN SE HAN RELACIONADO CON LAS ALTERACIONES DEL TAMAÑO DE LOS MELANOSOMAS, ASÍ COMO CON UN EFECTO CITOTÓXICO SOBRE LOS MELANOCITOS, PRODUCIDO POR ÁCIDOS DICARBOXÍLICOS QUE INHIBEN LA TIROSINASA, Y TIENEN EFECTO ANTIBACTERIANO.
TAMBIÉN PUEDEN EXPLICAR ESTAS ALTERACIONES PIGMENTARIAS METABOLITOS LIPÍDICOS DEPENDIENTES DE TIROSINASA, COMO PITIRIACITRINA Y PITIRIALACTONA.
POR OTRA PARTE, MALASSEZIA ES CAPAZ DE PRODUCIR IN VITRO UN PIGMENTO SEMEJANTE A LA MELANINA.
EN LA MÁS RECIENTE CLASIFICACIÓN DEL GÉNERO MALASSEZIA SE HAN RECONOCIDO 14 ESPECIES, DE ACUERDO CON SU MORFOLOGÍA, FISIOLOGÍA Y CARACTERÍSTICAS MOLECULARES: M. FURFUR, M. PACHYDERMATIS, M. SYMPODIALIS, M. GLOBOSA, M. SLOOFFIAE, M. RESTRICTA, M. OBTUSA, M. DERMATIS, M. JAPONICA, M. NANA, M. YAMATOENSIS, M. EQUI, M. CAPRAE, M. CUNICULI, M. VERPERTILIONIS, M. ARUNALOKEI.
SE AÍSLAN FUNDAMENTALMENTE M. GLOBOSA (97%), AUNADA A M. SYMPODIALIS EN CERCA DE 33% DE LOS CASOS; M. SLOOFFIAE (7%) Y M. FURFUR SON MÁS RARAS.
EN EL TRONCO SE HAN AISLADO M. SYMPODIALIS, M. GLOBOSA, M. FURFUR Y M. SLOOFFIAE, MIENTRAS QUE, EN LA PIEL CABELLUDA, ADEMÁS DE ESTAS ESPECIES SE HA AISLADO M. RESTRICTA, Y A PARTIR DE ESCAMAS DEL CONDUCTO AUDITIVO EXTERNO SE HAN AISLADO M. RESTRICTA, M. GLOBOSA Y M. SYMPODIALIS. EN PACIENTES CON PSORIASIS SE HA IDENTIFICADO VINCULACIÓN DE M. SYMPODIALIS Y M. SLOOFFIAE, SEGUIDA DE M. SYMPODIALIS Y M. FURFUR.
¿MANIFESTACIONES CLÍNICAS DE PITIRIASIS VERSICOLOR?
LAS LESIONES MUESTRAN DISTRIBUCIÓN CENTRÍPETA EN TÓRAX, ESPALDA Y PARTE PROXIMAL DE LAS EXTREMIDADES (FIG. 95-1); RARA VEZ SE EXTIENDEN AL CUELLO, LOS ANTEBRAZOS O LA PORCIÓN DISTAL DE LAS EXTREMIDADES; EN NIÑOS PUEDEN AFECTAR CARA, FRENTE Y REGIONES PREAURICULARES, Y EN LOS LACTANTES, LA ZONA DEL PAÑAL (FIG. 95-2).
SE HA OBSERVADO PRINCIPALMENTE EN ZONAS DEL CUERPO CON TEMPERATURA Y HUMEDAD ALTAS.
LA DERMATOSIS ESTÁ CONSTITUIDA POR ABUNDANTES MANCHAS LENTICULARES HIPOCRÓMICAS, DE COLOR CAFÉ (MARRÓN) O ROSADO (FIGS. 95-1 A 95-3).
PUEDE HABER UN “SEUDOBORDE” ACTIVO, OTRA FORMA CON MÁCULAS OSCURAS (PITIRIASIS VERSICOLOR NIGRA), ASÍ COMO LA TRANSFORMACIÓN GRADUAL DE UNA A OTRA O A LA FORMA ALBA.
MIDEN 2 A 4 MM DE DIÁMETRO O HASTA 1 O 2 CM; ESTÁN CUBIERTAS POR DESCAMACIÓN FURFURÁCEA; A VECES SON LESIONES FOLICULARES. CASI TODAS SON AISLADAS, PERO PUEDEN CONFLUIR Y FORMAR GRANDES PLACAS (FIG. 95-4).
LAS LESIONES SON DE EVOLUCIÓN CRÓNICA Y ASINTOMÁTICA, AUNQUE EN OCASIONES HAY PRURITO LEVE.
EN PERSONAS CON ALTERACIONES INMUNITARIAS AFECTA REGIONES POCO FRECUENTES, COMO CABEZA Y GENITALES. PUEDE SER UNA DERMATOSIS LOCALIZADA, DISEMINADA O ERITRODÉRMICA, Y POR SU MORFOLOGÍA, PUNTEADA, NUMULAR, RETICULAR, FOLICULAR O SEUDOPAPULAR, HIPERCRÓMICA, HIPOCRÓMICA Y ATRÓFICA (FIG. 95-5).
LA FOLICULITIS POR MALASSEZIA AFECTA A PERSONAS JÓVENES CON ANTECEDENTES DE TRATAMIENTO CON GLUCOCORTICOIDES O ANTIBIÓTICOS (TETRACICLINAS), USO DE ROPA OCLUSIVA, ASÍ COMO CON DIABETES O INMUNODEPRESIÓN O INMUNOSUPRESIÓN (P. EJ., RECEPTORES DE TRASPLANTE, ENFERMOS DE SIDA).
PREDOMINA EN TRONCO, CUELLO Y PARTE SUPERIOR DE LOS BRAZOS; ESTÁ CONSTITUIDA POR PÁPULAS FOLICULARES PRURIGINOSAS CON UN TAPÓN QUERATÓSICO, O CON PÚSTULAS (FIG. 95-6).
LA PUSTULOSIS CEFÁLICA NEONATAL SE PRESENTA COMO ERUPCIONES PUSTULARES O PAPULOPUSTULARES EN LA CARA, SIMILARES AL ACNÉ O LA MILIARIA SEBÁCEA.
LA ONICOMICOSIS ES MOTIVO DE CONTROVERSIA Y SON EXCEPCIONALES LA DACRIOCISTITIS Y LA INFECCIÓN SISTÉMICA; ESTA ÚLTIMA SE OBSERVA EN LOS RECIÉN NACIDOS O EN PACIENTES CON CATÉTERES, ASÍ COMO EN ADULTOS INMUNODEPRIMIDOS CON ENFERMEDAD GASTROINTESTINAL O QUE RECIBEN HIPERALIMENTACIÓN PARENTERAL LIPÍDICA.
SE OBSERVA FUNGEMIA Y PUEDE HABER MANIFESTACIONES PULMONARES, ADEMÁS DE PÚSTULAS EN LA PIEL; LA RELACIÓN CON PAPILOMATOSIS CONFLUENTE Y RETICULADA SE COMENTA EN EL CAPÍTULO 165, AUNQUE SU PRESENCIA PARECE DEBERSE A LA HIPERQUERATOSIS, MÁS QUE A UN EFECTO PATOGÉNICO Y SE HA RELACIONADO CON UN ACTINOMICETO AEROBIO GRAMPOSITIVO, DIETZIA PAPILLOMATOSIS. RECIENTEMENTE SE HA DESCRITO UNA FORMA PROFUNDA GRANULOMATOSA.

¿HISTOPATOLOGÍA DE LA PITIRIASIS VERSICOLOR?
LA TINCIÓN CON HEMATOXILINA Y EOSINA, ÁCIDO PERYÓDICO DE SCHIFF (PAS) O COLORANTE DE GOMORI-GROCOTT PUEDE PONER DE MANIFIESTO LEVADURAS Y FILAMENTOS EN LA CAPA CÓRNEA HIPERQUERATÓSICA O EN EL INFUNDÍBULO DEL PELO.
EN LA FOLICULITIS SE DEMUESTRAN EL HONGO EN EL TAPÓN QUERATÓSICO INFUNDIBULAR Y REACCIÓN INFLAMATORIA LEVE O GRANULOMATOSA.

¿DIAGNÓSTICO DE PITIRIASIS VERSICOLOR?
EL DIAGNÓSTICO SE SOSPECHA POR LA CLÍNICA.
SI SE RASPA CON UNA CUCHARILLA O CON LA UÑA, QUEDA UNA MARCA EN LA PIEL POR DESPRENDIMIENTO DE LAS ESCAMAS (SIGNO DE BESNIER O DEL UÑAZO).
CON LUZ DE WOOD SE OBSERVAN MEJOR LAS LESIONES CLÍNICAS (DE COLOR AMARILLO-DORADO), SOBRE TODO AQUELLAS POCO NOTORIAS (FIG. 95-7). CON LA IMPLEMENTACIÓN DE LA DERMATOSCOPIA SE HA FACILITADO EL DIAGNÓSTICO (FIG. 95-5).
EN EL EXAMEN DIRECTO CON POTASA AL 20 A 40%, O CON LA PRUEBA DE LA CINTA ADHESIVA TRANSPARENTE (SCOTCH TAPE TEST) SE APRECIAN LAS ESPORAS DE 3 A 6 ΜM EN RACIMOS DE UVAS, Y LOS FILAMENTOS CORTOS. ESTA OBSERVACIÓN ES MÁS EVIDENTE CON EL USO DE TINTA PARKER AZUL, O NEGRO DE CLORAZOL (FIG. 95-8).
UNA TÉCNICA SENCILLA Y FIDEDIGNA ES LA BIOPSIA DE SUPERFICIE CON CIANOACRILATO Y TINCIÓN DE PAS (ÁCIDO PERYÓDICO DE SCHIFF).
EN FOLICULITIS ES MÁS PRÁCTICA, SENSIBLE Y ESPECÍFICA LA TINCIÓN DE GRAM.
EL CULTIVO DEBE REALIZARSE EN MEDIOS ENRIQUECIDOS CON LÍPIDOS, COMO ACEITE DE OLIVA AL 10% O DIXON MODIFICADO (FIG. 95-9).
TODAS LAS ESPECIES SON LIPOFÍLICAS, CON EXCEPCIÓN DE M. PACHYDERMATIS; LA IDENTIFICACIÓN DE LAS DIFERENTES ESPECIES ES MUY COMPLEJA Y SE BASA EN PRUEBAS BIOQUÍMICAS.
LA INTRADERMORREACCIÓN NO SE USA EN LA PRÁCTICA. LO MÁS PRECISO SON LOS MÉTODOS MOLECULARES COMO LA CARIOTIPIFICACIÓN, EL ANÁLISIS POR POLIMORFISMO DE LA LONGITUD DE LOS FRAGMENTOS DE RESTRICCIÓN (RESTRICTION FRAGMENT LENGTH POLYMORPHISM [RFLP]), SECUENCIAS DE RNA Y DNA, Y CARACTERÍSTICAS FISIOLÓGICAS COMO LA ASIMILACIÓN DE DIFERENTES FUENTES DE LÍPIDOS.
SE HA DESARROLLADO UNA PCR MÚLTIPLEX PARA 11 ESPECIES DE MALASSEZIA TANTO DIRECTAMENTE DE PIEL COMO DE CULTIVOS.